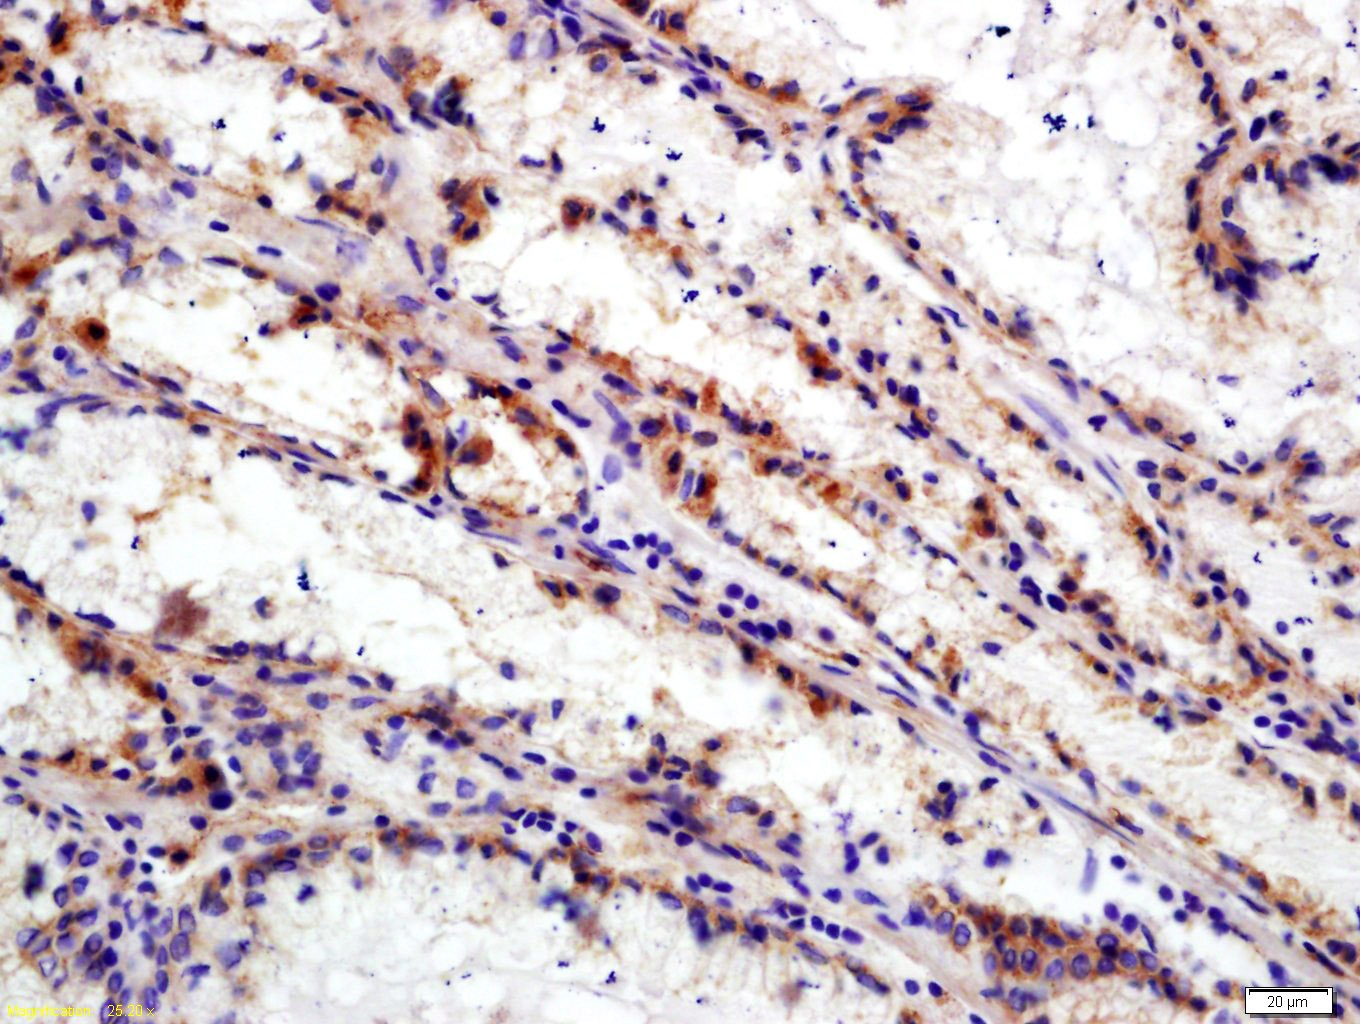

您的购物车当前为空
您的购物车当前为空
Anti-Integrin alpha 5 beta 6 Polyclonal Antibody
Synonyms: Vitronectin receptor subunit alpha, ITGB6, ITGAV, ITAV, Integrin, beta 6, integrin, alpha V(vitronectin receptor, alpha polypeptide, antigen CD51), Integrin, alpha V, Integrin alpha-V light chain, Integrin alpha 5 beta 6, CD51, avb6货号 TMAB-00981 一键复制产品信息
Anti-Integrin alpha 5 beta 6 Polyclonal Antibody 是一种 Rabbit 抗体,靶向 Integrin alpha 5 beta 6。Anti-Integrin alpha 5 beta 6 Polyclonal Antibody 可用于 FCM, ICC/IF, IF, IHC-Fr, IHC-P, WB。
Anti-Integrin alpha 5 beta 6 Polyclonal Antibody
一键复制产品信息货号 TMAB-00981
别名 Vitronectin receptor subunit alpha, ITGB6, ITGAV, ITAV, Integrin, beta 6, integrin, alpha V(vitronectin receptor, alpha polypeptide, antigen CD51), Integrin, alpha V, Integrin alpha-V light chain, Integrin alpha 5 beta 6, CD51, avb6
Anti-Integrin alpha 5 beta 6 Polyclonal Antibody 是一种 Rabbit 抗体,靶向 Integrin alpha 5 beta 6。Anti-Integrin alpha 5 beta 6 Polyclonal Antibody 可用于 FCM, ICC/IF, IF, IHC-Fr, IHC-P, WB。
Anti-Integrin alpha 5 beta 6 Polyclonal Antibody
| 规格 | 价格 | 库存 | 数量 |
|---|---|---|---|
| 50 μL | ¥ 1,170 | 5日内发货 | |
| 100 μL | ¥ 1,960 | 5日内发货 | |
| 200 μL | ¥ 2,790 | 5日内发货 |
库存状态实时更新,以官网显示为准,现货产品可直接加购物车下单
大包装 & 定制
加入购物车
TargetMol的所有产品仅用作科学研究或药证申报,不能被用于人体,我们不向个人提供产品和服务。请您遵守承诺用途,不得违反法律法规规定用于任何其他用途。
产品介绍
生物活性
抗原信息
化学信息
储存&溶解度
| 产品描述 | Anti-Integrin alpha 5 beta 6 Polyclonal Antibody is a Rabbit antibody targeting Integrin alpha 5 beta 6. Anti-Integrin alpha 5 beta 6 Polyclonal Antibody can be used in FCM, ICC/IF, IF, IHC-Fr, IHC-P, WB. |
| 别名 | Vitronectin receptor subunit alpha, ITGB6, ITGAV, ITAV, Integrin, beta 6, integrin, alpha V(vitronectin receptor, alpha polypeptide, antigen CD51), Integrin, alpha V, Integrin alpha-V light chain, Integrin alpha 5 beta 6, CD51, avb6 |
| Ig Type | IgG |
| 反应种属 | Human (predicted:Mouse,Rat,Chicken,Dog,Pig,Cow,Horse) |
| 验证活性 | 1. Tissue/cell: human gastric carcinoma; 4% Paraformaldehyde-fixed and paraffin-embedded; Antigen retrieval: citrate buffer (0.01M, pH6.0), Boiling bathing for 15 min; Block endogenous peroxidase by 3% Hydrogen peroxide for 30 min; Blocking buffer (normal goat serum) at 37°C for 20 min; Incubation: Anti-Integrin Alpha V+Beta 6 Polyclonal Antibody, Unconjugated (TMAB-00981) 1:200, overnight at 4°C, followed by conjugation to the secondary antibody and DAb staining. 2. Blank control (blue): Hela (fixed with 2% paraformaldehyde (10 min), then permeabilized with 90% ice-cold methanol for 30 min on ice). Primary Antibody: Rabbit Anti-Integrin Alpha V + Beta 6 antibody (TMAB-00981), Dilution: 1 μg in 100 μL 1X PBS containing 0.5% BSA; Isotype Control Antibody: Rabbit Igg (orange),used under the same conditions); Secondary Antibody: Goat anti-rabbit IgG-Pe (white blue), Dilution: 1:200 in 1 X PBS containing 0.5% BSA. 3. Sample: Lane 1: A549 (Human) Cell Lysate at 30 μg Lane 2: MCF-7 (Human) Cell Lysate at 30 μg Lane 3: Huvec (Human) Cell Lysate at 30 μg Primary: Anti-CD51 (TMAB-00981) at 1/1000 dilution Secondary: IRDye800CW Goat Anti-Rabbit IgG at 1/20000 dilution Predicted band size: 125-140 kDa Observed band size: 140 kDa |
| 应用 | FCMICC/IFIFIHC-FrIHC-PWB |
| 推荐剂量 | FCM=1 μg/Test; ICC/IF=1:100-500; IF=1:100-500; IHC-Fr=1:100-500; IHC-P=1:100-500; WB=1:1000-10000 |
| 抗体种类 | Polyclonal |
| 宿主来源 | Rabbit |
| 亚细胞定位 | Cell Membrane |
| 构建方式 | Polyclonal Antibody |
| 纯化方式 | Protein A purified |
| 性状 | Liquid |
| 缓冲液 | 0.01M TBS (pH7.4) with 1% BSA, 0.02% Proclin300 and 50% Glycerol. |
| 浓度 | 1 mg/mL |
| 研究背景 | Integrins are heterodimeric proteins made up of alpha and beta subunits. At least 18 alpha and 8 beta subunits have been described in mammals. Integrin family members are membrane receptors involved in cell adhesion and recognition in a variety of processes including embryogenesis, hemostasis, tissue repair, immune response and metatastatic diffusion of tumour cells. ITAGV encodes integrin alpha chain V. Integrins are heterodimeric integral membrane proteins composed of an alpha chain and a beta chain. The I-domain containing integrin alpha V undergoes post-translational cleavage to yield disulfide-linked heavy and light chains, that combine with multiple integrin beta chains to form different integrins. Among the known associating beta chains (beta chains 1,3,5,6, and 8; ITGB1, ITGB3, ITGB5, ITGB6, and ITGB8), each can interact with extracellular matrix ligands; the alpha V beta 3 integrin, perhaps the most studied of these, is referred to as the Vitronectin receptor (VNR). In addition to adhesion, many integrins are known to facilitate signal transduction. |
| 免疫原 | KLH conjugated synthetic peptide: human Integrin Alpha V + Beta 6 |
| 抗原种属 | Human |
| 基因名称 | ITGAV |
| 基因ID | |
| 蛋白名称 | Integrin alpha-V |
| Uniprot ID | |
| 研究领域 | Integrins,Integrins,Platelets,Host Virus Interaction,T Lymphocytic Lineage |
| 功能 | The alpha-V integrins are receptors for vitronectin, cytotactin, fibronectin, fibrinogen, laminin, matrix metalloproteinase-2, osteopontin, osteomodulin, prothrombin, thrombospondin and vWF. They recognize the sequence R-G-D in a wide array of ligands. In case of HIV-1 infection, the interaction with extracellular viral Tat protein seems to enhance angiogenesis in Kaposi's sarcoma lesions. |
| 分子量 | Theoretical: 18/95/113 kDa. Actual: 140 kDa. |
| 储存方式 | Store at -20°C or -80°C for 12 months. Avoid repeated freeze-thaw cycles. |
| 运输方式 | Shipping with blue ice. |
计算器
Related Tags: buy Anti-Integrin alpha 5 beta 6 Polyclonal Antibody | purchase Anti-Integrin alpha 5 beta 6 Polyclonal Antibody | Anti-Integrin alpha 5 beta 6 Polyclonal Antibody cost | order Anti-Integrin alpha 5 beta 6 Polyclonal Antibody | Anti-Integrin alpha 5 beta 6 Polyclonal Antibody molecular weight





 还可以
还可以
 |
|